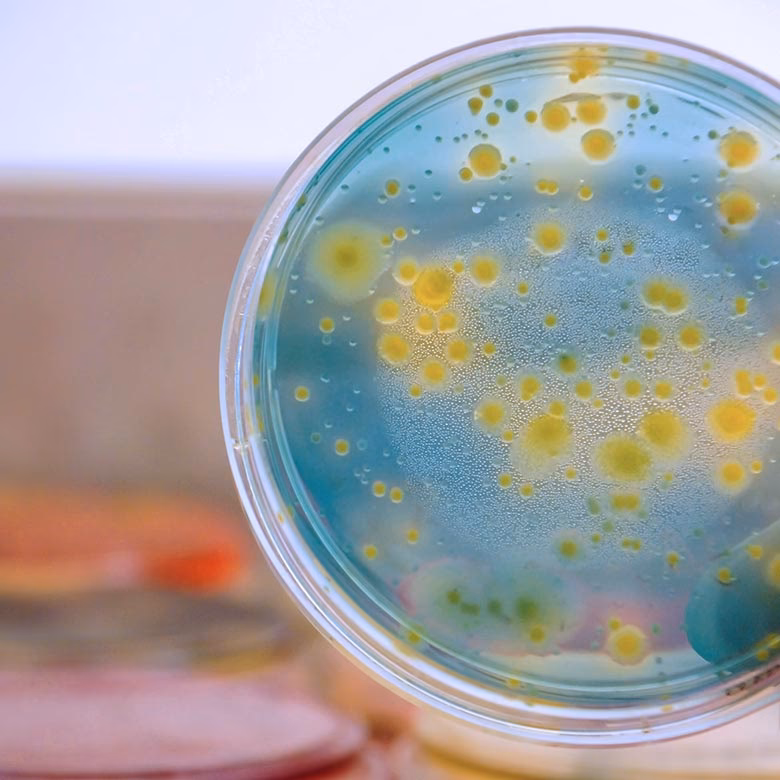
¿Cómo evitar la candidemia?

03/04/2010
En el vasto universo de la salud humana, a menudo nos enfocamos en amenazas visibles como virus y bacterias, pero existe un reino de organismos que, en silencio, pueden causar estragos cuando nuestro equilibrio interno se rompe. Hablamos de los hongos, y en particular, de la candidemia, una infección sanguínea grave causada por levaduras del género Candida. Aunque suene como un problema puramente médico, sus raíces son mucho más profundas y se entrelazan con el ecosistema de nuestro propio cuerpo y el entorno que nos rodea. Este artículo explora no solo qué es la candidemia, sino cómo una perspectiva ecológica sobre nuestra salud es fundamental para su prevención.
Eliminar factores predisponentes: Retirar SV Antifúngicos no recomendados: Excepto alto riesgo de diseminación: –Neutropénicos –Neonatos bajo peso (<1500 g) –Manipulaciones urológicas = Candidemia strong recommendation; low-quality FLU 6mg/kg/dia Pappas et al. IDSA 2016.[/caption]
Eliminar factores predisponentes: Retirar SV Antifúngicos no recomendados: Excepto alto riesgo de diseminación: –Neutropénicos –Neonatos bajo peso (<1500 g) –Manipulaciones urológicas = Candidemia strong recommendation; low-quality FLU 6mg/kg/dia Pappas et al. IDSA 2016.[/caption]
¿Qué es Exactamente la Candidemia?
Para entender cómo evitarla, primero debemos comprender a nuestro adversario. La Candida, especialmente la especie Candida albicans, es un habitante común y generalmente inofensivo de nuestro cuerpo. Vive en nuestra piel, en la boca, en el tracto digestivo y en la zona genital, formando parte de un complejo y delicado ecosistema conocido como el microbioma. En una persona sana, su población está controlada por las bacterias beneficiosas y un sistema inmunitario robusto.
El problema surge cuando este equilibrio se rompe. La candidemia ocurre cuando esta levadura se vuelve oportunista: aprovecha una debilidad en nuestras defensas, prolifera sin control y logra acceder al torrente sanguíneo. Una vez en la sangre, puede viajar a órganos vitales como el corazón, el cerebro, los ojos y los riñones, causando infecciones potencialmente mortales. Es, por tanto, una condición que afecta principalmente a individuos con sistemas inmunitarios comprometidos o que se encuentran en entornos hospitalarios.
El Eslabón Perdido: Nuestro Ecosistema Interno y el Medio Ambiente
Aquí es donde la visión ecologista cobra una importancia crucial. Debemos dejar de ver nuestro cuerpo como una máquina y empezar a verlo como lo que es: un ecosistema andante. La salud no es la ausencia de gérmenes, sino la presencia de un equilibrio dinámico entre miles de millones de microorganismos. Cualquier factor que altere este equilibrio puede abrir la puerta a infecciones como la candidemia.
Factores que Rompen Nuestro Equilibrio Interno
La información clínica es clara al señalar "factores predisponentes" como la causa principal. Estos no son solo elementos médicos, sino también reflejos de nuestro estilo de vida y entorno.
- Uso Excesivo de Antibióticos: Los antibióticos son un arma de doble filo. Si bien salvan vidas al combatir infecciones bacterianas, actúan como un "herbicida de amplio espectro" en nuestro microbioma. Aniquilan tanto a las bacterias malas como a las buenas, dejando un vacío ecológico que la Candida, al ser un hongo y no ser afectada por ellos, aprovecha para crecer descontroladamente. El uso indiscriminado de antibióticos en la medicina y, de forma aún más alarmante, en la ganadería industrial, contribuye a este desequilibrio a escala global.
- Dispositivos Médicos Invasivos: Catéteres venosos centrales (a lo que se refiere "Retirar SV"), sondas y otros dispositivos crean una autopista directa para que los microorganismos de la piel, incluida la Candida, accedan al torrente sanguíneo. Una gestión cuidadosa y la retirada de estos dispositivos tan pronto como sea posible es una medida de prevención fundamental.
- Sistema Inmunitario Debilitado: Pacientes neutropénicos (con niveles bajos de un tipo de glóbulo blanco), neonatos de bajo peso, pacientes con cáncer bajo quimioterapia o personas con enfermedades autoinmunes tienen sus defensas naturales mermadas. Su "policía" interna no puede mantener a raya a los oportunistas.
- Dieta Moderna y Estrés: Una dieta alta en azúcares refinados y carbohidratos procesados puede alimentar el crecimiento de levaduras como la Candida. El estrés crónico, por su parte, debilita el sistema inmunitario, haciendo que nuestro cuerpo sea menos capaz de mantener el equilibrio microbiano.
La Prevención: Un Enfoque Holístico y Proactivo
La estrategia para evitar la candidemia debe ir más allá de simplemente reaccionar con fármacos. Si bien los antifúngicos como el Fluconazol (FLU) son vitales en el tratamiento de una infección establecida y en la profilaxis de pacientes de altísimo riesgo (como los mencionados neonatos de bajo peso o pacientes neutropénicos), su uso preventivo generalizado no está recomendado. ¿Por qué? Porque, al igual que los antibióticos, pueden generar resistencias y no abordan la causa raíz del problema: el desequilibrio.
La verdadera prevención reside en fortalecer la resiliencia de nuestro ecosistema interno y minimizar los factores que lo perturban.
Tabla Comparativa: Dos Enfoques para un Mismo Problema
| Característica | Enfoque Clínico Reactivo | Enfoque Ecológico Proactivo |
|---|---|---|
| Foco Principal | Tratar la infección una vez establecida. Profilaxis en grupos de muy alto riesgo. | Fortalecer el sistema inmune y el microbioma para evitar que la infección ocurra. |
| Herramientas Clave | Antifúngicos (ej. Fluconazol), retirada de catéteres. | Dieta equilibrada, probióticos, uso racional de antibióticos, gestión del estrés, higiene. |
| Perspectiva | La Candida es el enemigo a eliminar. | El desequilibrio del ecosistema interno es el problema a corregir. La Candida es un síntoma. |
| Aplicación | Principalmente en entorno hospitalario y para pacientes de alto riesgo. | Aplicable a toda la población, en todo momento, como estrategia de salud a largo plazo. |
Preguntas Frecuentes (FAQ)
¿La candidemia es contagiosa?
No, la candidemia no se considera una enfermedad contagiosa de persona a persona. Es una infección endógena, lo que significa que se origina a partir de la propia flora de Candida del individuo cuando sus defensas bajan y la levadura accede al torrente sanguíneo.
¿Tomar probióticos puede ayudar a prevenir la candidemia?
Si bien no hay una garantía absoluta, fortalecer el microbioma intestinal con probióticos (bacterias beneficiosas) puede ayudar a mantener a raya a la Candida. Un intestino saludable y equilibrado es una barrera de defensa crucial. Es una pieza importante dentro de una estrategia integral de salud.
¿Qué tiene que ver mi alimentación con una infección en la sangre?
Muchísimo. Una dieta rica en azúcares y alimentos procesados puede promover el crecimiento excesivo de Candida en el intestino. Este sobrecrecimiento (conocido como candidiasis intestinal) aumenta el riesgo de que la levadura pueda, eventualmente, traspasar la barrera intestinal y llegar a la sangre si se presentan otros factores de riesgo, como un sistema inmune debilitado.
Si no estoy en un hospital, ¿debo preocuparme?
La candidemia es rara en personas sanas con un sistema inmunitario fuerte. Sin embargo, los principios para prevenirla son los mismos que para mantener una buena salud general: cuidar nuestro microbioma, llevar una dieta equilibrada, evitar el uso innecesario de antibióticos y gestionar el estrés. Estas acciones nos hacen más resilientes no solo contra la Candida, sino contra una multitud de problemas de salud.
En conclusión, la candidemia es mucho más que un diagnóstico médico; es una señal de alarma de un ecosistema interno profundamente alterado. La prevención más eficaz no se encuentra únicamente en un frasco de antifúngicos, sino en un enfoque consciente y respetuoso hacia nuestro propio cuerpo y el entorno. Al cuidar nuestro microbioma, al exigir un uso más responsable de los antibióticos en todos los sectores y al adoptar un estilo de vida que promueva el equilibrio, no solo cerramos la puerta a esta grave infección, sino que construimos una base de salud más sólida y sostenible para el futuro.
Si quieres conocer otros artículos parecidos a Candidemia: La Amenaza Oculta en el Desequilibrio puedes visitar la categoría Ecología.

